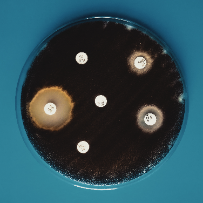
Profile picture

Dominik Łagowski
Doctorate
-
Assistant ProfessorPoznan University of Life SciencesPoznan, Poland
